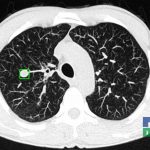

Examinare de rutină cerebrală, nativ și cu substanță de contrast (SDC) pentru diagnosticul:
- Accidentelor vasculare cerebrale ischemice sau hemoragice
- Tumorilor cerebrale
În cazul traumatismelor cranio-cerebrale:
- Evaluarea deplasării liniei mediane
- Evaluarea cisternelor perimezencefalice
- Diagnosticul edemului cerebral, a contuziei cerebrale, a leziunilor axonale difuze edematoase/hemoragice, a dilacerării cerebrale, a hematomului intraparenchimatos posttraumatic, a hematoamelor subdurale/extradurale (acute, subacute, cronice), a hemoragiei intraventriculare, a hemoragiei subarahnoidiene
- Diagnosticul traumatismelor de bază de craniu
- Diagnosticul fistulei LCR
- Diagnosticul herniilor cerebrale
- Diagnosticul fracturilor:
-
- Unice
- Multiple
- Cu înfundare
- Complexe cranio-sinusale
- Complexe cranio-etmoidale
- Complexe cranio-orbitare
- Complexe cranio-faciale
- Accidentelor vasculare cerebrale ischemice sau hemoragice
- Tumorilor cerebrale:
-
- Empiemul subdural
- Abcesul cerebral
- Fistula carotido-cavernoasa
- Higroma
- Atrofia cerebrală regională